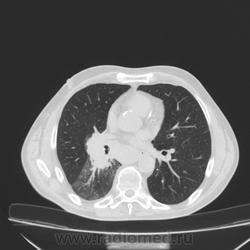
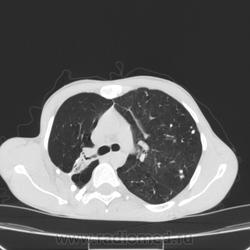

Пол пациента:
Тип патологии:
Область исследования:
Методы исследования:
Молодой человек 30 лет, в 04 году выявлен фиброзно-кавернозный ТБ, в течение 12 месяцев лечился в стационаре, прооперирован-5реберная торакопластика справа, через 3 года переведен в 3ГДУ, в 10году снят с ДУ по излечению. Пришел провериться по ухудшению состояния. На КТ легких данных за рецидив ТБ, вроде нет. С " торакопластикой" был единственным пациентом на учете.
- https://radiomed.ru/sites/default/files/styles/case_slider_image/public/user/16789/img-0002-00001_20.jpg?itok=_m_g1s24
- https://radiomed.ru/sites/default/files/styles/case_slider_image/public/user/16789/img-0002-00001_21.jpg?itok=ILai7X8x
- https://radiomed.ru/sites/default/files/styles/case_slider_image/public/user/16789/img-0003-00001_17.jpg?itok=1IwEAJ7D
- https://radiomed.ru/sites/default/files/styles/case_slider_image/public/user/16789/img-0004-00001_16.jpg?itok=EqoLSP1J
- https://radiomed.ru/sites/default/files/styles/case_slider_image/public/user/16789/img-0006-00001_11.jpg?itok=nMGUemDh
- https://radiomed.ru/sites/default/files/styles/case_slider_image/public/user/16789/img-0007-00001_13.jpg?itok=9ZddLbPg
- https://radiomed.ru/sites/default/files/styles/case_slider_image/public/user/16789/img-0009-00001_9.jpg?itok=_adFwJmL
- https://radiomed.ru/sites/default/files/styles/case_slider_image/public/user/16789/img-0010-00001_9.jpg?itok=rqSjJB_E
- https://radiomed.ru/sites/default/files/styles/case_slider_image/public/user/16789/img-0011-00001_6.jpg?itok=18QmNXbg
- https://radiomed.ru/sites/default/files/styles/case_slider_image/public/user/16789/img-0012-00001_9.jpg?itok=rrmBVYXZ
- https://radiomed.ru/sites/default/files/styles/case_slider_image/public/user/16789/img-0013-00001_7.jpg?itok=xK0TvXJC
- https://radiomed.ru/sites/default/files/styles/case_slider_image/public/user/16789/img-0014-00001_5.jpg?itok=fBLr6yrl
- https://radiomed.ru/sites/default/files/styles/case_slider_image/public/user/16789/img-0015-00001_3.jpg?itok=dAxFs_X_
- https://radiomed.ru/sites/default/files/styles/case_slider_image/public/user/16789/img-0016-00001_4.jpg?itok=tomi6fez
- https://radiomed.ru/sites/default/files/styles/case_slider_image/public/user/16789/img-0017-00001_3.jpg?itok=soC-vZID
- https://radiomed.ru/sites/default/files/styles/case_slider_image/public/user/16789/img-0018-00001_2.jpg?itok=RkszegnH
- https://radiomed.ru/sites/default/files/styles/case_slider_image/public/user/16789/img-0019-00001_3.jpg?itok=-BgbdDLY
- https://radiomed.ru/sites/default/files/styles/case_slider_image/public/user/16789/img-0020-00001_2.jpg?itok=6IvGk-Ef
- https://radiomed.ru/sites/default/files/styles/case_slider_image/public/user/16789/img-0021-00001_3.jpg?itok=1_DlTAfr
- https://radiomed.ru/sites/default/files/styles/case_slider_image/public/user/16789/img-0022-00001_1.jpg?itok=XMZG75rI
- https://radiomed.ru/sites/default/files/styles/case_slider_image/public/user/16789/img-0023-00001_0.jpg?itok=W7DOJEJ5
- https://radiomed.ru/sites/default/files/styles/case_slider_image/public/user/16789/img-0024-00001.jpg?itok=t1bymx1-
- https://radiomed.ru/sites/default/files/styles/case_slider_image/public/user/16789/img-0025-00001.jpg?itok=czGqVY8x
- https://radiomed.ru/sites/default/files/styles/case_slider_image/public/user/16789/img-0026-00001.jpg?itok=LqtwAF7Z
ID:30607

Состояние после правосторонней 5-реберной торакопластики по поводу ФКТ.Грубые остаточные изменения:поликистоз,буллезно-дистрофические изменения,плевропневмоцирроз правого легкого..Нет ли мелкоочаговой диссеминации в обоих легких?Нужен Rархив.(ПТД).
Нет, это кальцинаты и более плотные уже. Архив только пленочный, 8 лет назад "цифры" не было. Можно и пленку перефотать...
Редко встречалось, а на КТ вижу впервые, спасибо за случай! На показанных изображениях отсевов не увидела.
"Предоставляя весь смысл и совершенство в распоряжение одного только Бога, вы избавляете себя от бездны хлопот." Джон Уитборн.
На здоровье! Покажу еще кучу больных, есть интересные, есть не очень.
Показывайте!
За комменты не ручаюсь.
За интерес к публикациям огромный (по количеству просмотров) ручаюсь!